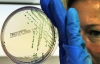
Смертоносная бактерия E.coli подбирается к Украине

Двухлетний мальчик умер из-за кишечной инфекции в германской земле Нижняя Саксония, число жертв выросло до 37 человек.
"Врачи сделали все возможное, чтобы спасти его жизнь... К сожалению, все бесполезно", - сказал представитель клиники в Ганновере Штефан Цорн. В Ганновер ребенка перевезли из клиники в городке Ольденбург 5 июня. Мальчик умер от почечной недостаточности, развившейся из-за заражения инфекцией, а также из-за разрушения эритроцитов. Не помогли ни разные формы терапии, ни переливание крови.
Отец и десятилетний брат умершего также заразились инфекцией. Как отмечают врачи, сын и отец поправляются.
Вспышка кишечной инфекции изначально была зафиксирована на севере Германии. Сначала предполагалось, что переносчиком опасных бактерий являются салатные огурцы из Испании, но это предположение не подтвердилось. Затем специалисты заявили, что источником инфекции могла стать ферма в Нижней Саксонии, которая поставляет на рынки страны пророщенную сою и другие злаки, используемые для приготовления салатов и вторых блюд.
Инфекцию вызвала так называемая энтерогеморрагическая бактерия Escherichia coli (кишечная палочка). Бактерия E.coli часто присутствует в кишечнике людей и теплокровных животных. Большинство ее штаммов безвредны, но некоторые штаммы, такие, как энтерогеморрагическая кишечная палочка (EHEC), могут вызывать тяжелые болезни пищевого происхождения.
Симптомы вызываемых бактериями EHEC болезней - кровавая диарея, жар и рвота. Большинство пациентов выздоравливает в течение десяти дней, но у незначительного числа пациентов (детей раннего возраста и пожилых людей) болезнь может принять тяжелую форму с угрозой для жизни.

Комментарии